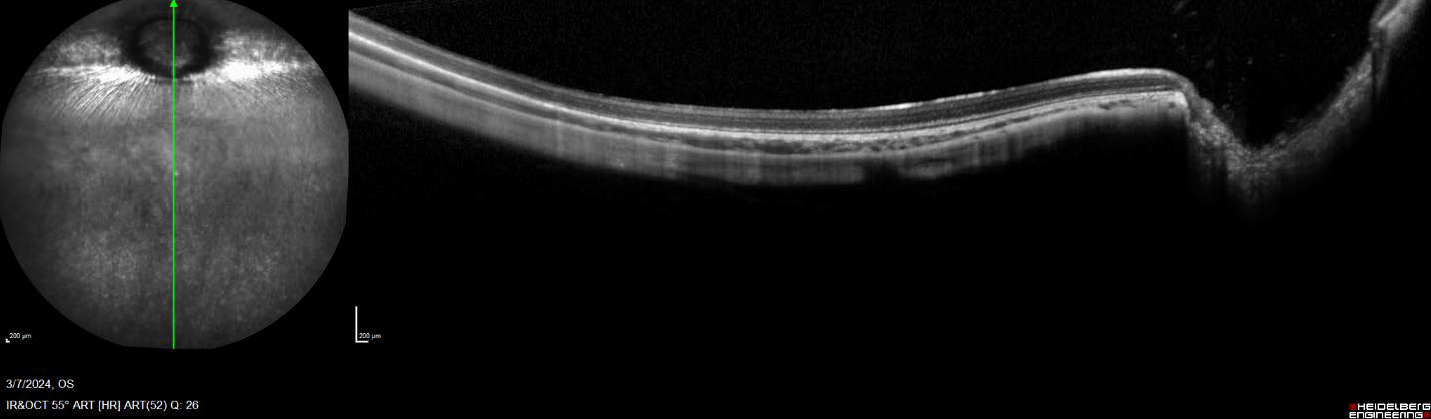

Biochemistry & Bioanalytical
Ocular Readouts
Elevate Your Ocular Research with GD3. Our comprehensive ocular assessments offer unparalleled insights into pharmacokinetic and pharmacodynamic studies. With advanced readouts, meticulously track changes in intraocular pressure, visual function, and beyond, gaining valuable data to drive your therapeutic development. Rely on GD3's scientific expertise to enhance your research and pioneer innovative solutions in ocular drug discovery.
In Vivo Readouts:
-
The intraocular pressure within the eye is maintained through a precise equilibrium involving the production and drainage of aqueous humor, which, when disturbed, can cause a wide range of ocular manifestations. The iCare Tonolab and Tonovet are devices that utilize the rebound measuring principle of a lightweight probe that is used to contact the cornea of subjects from preclinical ocular safety and efficacy studies. The scientific experts at GD3 use this technique as a means to longitudinally measure and monitor IOP levels, thereby providing the reliable and consistent data needed to assess the safety and efficacy of potential treatments.
 Figure 1. Intraocular pressure being collected from a rodent using the iCare Tonolab.
Figure 1. Intraocular pressure being collected from a rodent using the iCare Tonolab. -
Optical coherence tomography is an ocular imaging modality that employs a laser beam at varying wavelengths to provide cross-sectional images of ocular tissues. This non-invasive technique offers the opportunity to collect and analyze the longitudinal safety and efficacy data that is required to understand ocular disease pathology and the effectiveness of potential treatments. With the state-of-the-art Heidelberg Spectralis HRA+OCT system, the scientists at GD3 can provide personalized, high-resolution scanning and analysis strategies to meet your needs.
Figure 2. Vertical, single line, wide field OCT scan of a rabbit retina
Figure 2. Vertical, single line, wide field OCT scan of a rabbit retina Figure 3. Horizontal, single line, OCT scan of a mouse retina with 30º lens.
Figure 3. Horizontal, single line, OCT scan of a mouse retina with 30º lens. -
The confocal laser scanning ophthalmoscopy (cSLO) capability of the Heidelberg Spectralis HRA+OCT utilizes the tissue penetration and reflectance characteristics of multiple wavelengths to generate high-contrast fundic images. Additionally, through the use of the blue autofluorescence (BAF) and indocyanine green angiography (ICGA) settings, the scientists at GD3 can provide assessments that reveal the angiographic characteristics of the retinal and choroidal vasculature. Through the collection of real-time video recordings during and after fluorescein injection with our advanced fluorescein angiography (FA) procedure, these data can provide the information needed to assess the safety and efficacy of a variety of ocular disease models and therapeutics.
 Figure 4. Composite fluorescein angiography (FA) image of a rabbit retina post-fluorescein injection.
Figure 4. Composite fluorescein angiography (FA) image of a rabbit retina post-fluorescein injection. -
The electroretinogram involves the exposure of light stimuli of varying intensities and durations to the retina and measuring the electrical response that is generated in the form of a waveform. Importantly, these waveforms have characteristic markers that correspond and provide information on the function of a variety of cell populations within the retina that are essential for vision, and this concept has proven to be an invaluable tool for the safety and efficacy assessment for preclinical ocular investigations. Using the Celeris Diagnosys ERG system, the ocular scientists at GD3 are enabled to create and modify a variety of ERG protocols to provide the optimal and consistent data needed to advance therapeutic candidates.
 Figure 5. Celeris Diagnosys imaging platform is used to collect ERGs in rodents and rabbits.
Figure 5. Celeris Diagnosys imaging platform is used to collect ERGs in rodents and rabbits. -
The eye can broadly broken down into the anterior, posterior and vitreous chambers. The anterior chamber encompasses the space between the cornea and the iris, which is where the posterior begins and spans from the iris to the lens. Lastly, the vitreous chamber includes the space from the lens to the back of the eye. Although each chamber has anatomical and size differences, they all contain information from critical components used to generate vision. At GD3 we utilize the expertise of board-certified veterinary ophthalmologists to perform the slit lamp and indirect ophthalmological examinations needed to assess all three chambers on subjects from preclinical ocular investigations. The observations from these examinations are vital for monitoring disease progression, immunological response, and providing the potential treatments needed to optimize the results needed for the advancement of an ocular therapeutic.
Dr. Ryan Boyd, DVM, DAVCO Dr. Boyd brings over 17 years of experience in the CRO industry, including his Master of Science and DVM, as well as his DAVCO residency from Michigan State University. His extensive expertise in diagnosing and treating complex eye conditions, directing ocular programs, developing ocular models, and analyzing ocular endpoints will be invaluable to our team and our clients.
Clinical observations, food and water consumption, body weights
-
Terminal Readouts:
- Immunofluorescence and immunohistochemistry
- Histopathologic evaluation, including whole slide imaging
- Biomarker analysis via qPCR or ligand binding assay (LBA)
- Bioanalysis for test article detection via LC-MS/MS, LBA and qPCR
- Full necropsy capabilities, including extensive ocular dissection expertise
Learn more about Custom Model Development






















